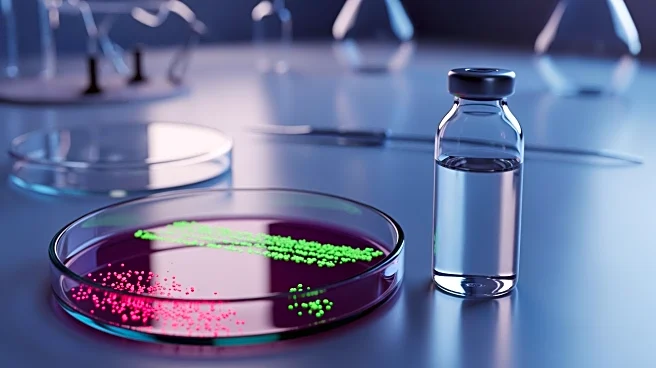
University of Sydney Researchers Discover New Antibiotics to Combat Tuberculosis

What's Happening?
Researchers at Northwestern University have developed a novel approach to combat cancer-driving proteins by utilizing protein-like polymers (PLPs) to direct these proteins to the cell's waste-disposal system. This method, detailed in a study published
in Nature Communications, involves the use of HYDRACs (HYbrid DegRAding Copolymers) to target and degrade proteins such as MYC and KRAS, which are known to drive aggressive cancers and resist conventional treatments. The HYDRACs work by binding to these proteins and facilitating their degradation, effectively reducing cancer cell proliferation and stalling tumor growth in animal models. This innovative approach offers a potential new pathway for treating cancers that have been difficult to target with existing drugs.
Why It's Important?
The development of HYDRACs represents a significant advancement in cancer treatment, particularly for cancers driven by proteins like MYC and KRAS, which have been notoriously difficult to target with traditional drugs. This new method could potentially lead to more effective treatments for a wide range of cancers, offering hope for patients with limited options. By targeting the proteins for degradation rather than attempting to block their activity, this approach circumvents the challenges posed by 'undruggable' proteins that lack suitable binding sites for small molecule drugs. The success of this method in preclinical models suggests it could be adapted to target other protein-related diseases, broadening its impact on public health.
What's Next?
Following the promising results in cancer models, the research team plans to adapt the HYDRACs technology to target proteins involved in other diseases, such as neurodegenerative, inflammatory, and metabolic disorders. Northwestern spinout Grove Biopharma has licensed the technology, aiming to accelerate its development into therapeutic applications. Future research will focus on expanding the range of target proteins and optimizing the platform for clinical use, potentially leading to new treatments that could transform the management of various protein-related diseases.